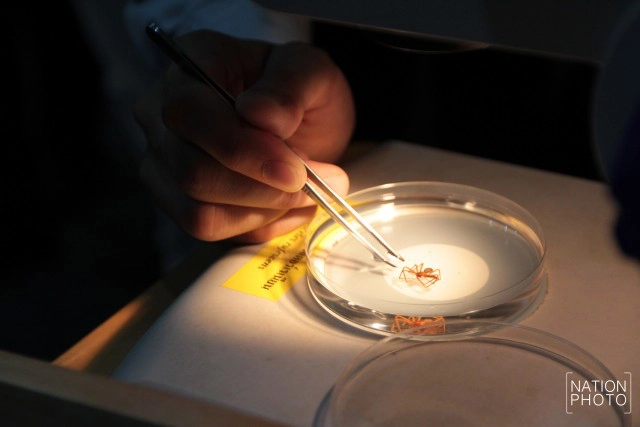
วิธีปฐมพยาบาลเบื้องต้น หากถูก"แมงมุมสันโดษ"กัด!

นพ.อนุชา เศรษฐเสถียร เลขาธิการสถาบันการแพทย์ฉุกเฉินแห่งชาติ (สพฉ.) กล่าวว่า แมงมุมสันโดษ จัดอยู่ในกลุ่มแมงมุมที่มีพิษร้ายแรงชนิดสำคัญของโลก โดยจะออกฤทธิ์ทั้งทางผิวหนังและทางระบบเลือด โดยแต่ละคนจะได้รับพิษรุนแรงไม่เท่ากัน แต่ส่วนใหญ่มักมีอาการไม่รุนแรง คันเป็นตุ่มแดงตามร่างกายเหมือนยุงกัด แต่หากถูกพิษมาก จะเกิดเป็นตุ่มน้ำพอง มีอาการปวดมากขึ้นเรื่อย ๆ และทำให้ผิวหนังบริเวณที่ถูกกัดตาย เกิดเป็นแผลเป็นขนาดใหญ่

ดังนั้น หากถูกแมงมุมสันโดษสีน้ำตาลกัด การปฐมพยาบาลเบื้องต้น คือควรล้างแผล และ ประคบน้ำแข็ง ยกบริเวณที่ถูกกัดให้สูงขึ้น ห้ามนวด หรือประคบด้วยน้ำร้อน หรือการบีบรัดบริเวณแผลโดยเด็ดขาด เนื่องจากจะทำให้พิษแมงมุมกระจาย ส่วนผู้ป่วยที่มีอาการทางระบบเลือด เลือดแข็งตัวผิดปกติ อาจต้องให้เลือดและสารที่มีผลทำให้เลือดแข็งตัว หรือถ้าไตวายอาจจะต้องฟอกไต อย่างไรก็ตาม หากมีอาการรุนแรงฉุกเฉินมาก ให้รีบโทรแจ้งสายด่วน 1669 เพื่อขอรับความช่วยเหลือทางการแพทย์ โดยเร็ว และที่สำคัญหากเป็นไปได้ควรนำตัวอย่างแมงมุมที่ถูกกัดมาให้แพทย์ด้วย เพื่อจะได้ระบุได้ชัดว่าเป็นแมงมุมที่มีพิษหรือไม่

อย่างไรก็ตาม เพื่อหลีกเลี่ยงความเสี่ยง ไม่ควรเข้าไปในบริเวณที่แคบ หรือถ้ำต่างๆ เพราะเป็นที่อาศัยของแมงมุมสันโดษเมดิเตอร์เรเนียน แต่หากจำเป็นควรใส่รองเท้าและเสื้อผ้าป้องกันให้มิดชิด เพราะส่วนใหญ่จะได้รับพิษจากการสัมผัส
วิธีปฐมพยาบาลเบื้องต้น หากถูกแมงมุมสันโดษกัด- ล้างแผล ประคบน้ำแข็ง ยกบริเวณที่ถูกกัดให้สูงขึ้น- ห้ามนวด หรือประคบน้ำร้อน หรือบีบรัดบริเวณแผลโดยเด็ดขาด เนื่องจากทำให้พิษแมงมุมกระจาย- ผู้ป่วยที่มีอาการทางระบบเลือด เลือดแข็งตัวผิดปกติ อาจต้องให้เลือดและสารที่ทำให้เลือดแข็งตัว หรือถ้าไตวาย อาจต้องฟอกไต

ลักษณะเด่น- ลำตัวสีน้ำตาลเข้มมองแล้วคล้ายกับไวโอลิน-ขนาดตัวประมาณ 7 มิลลิเมตร- พบบริเวณถ้ำเขตทหาร อ.ไทรโยค จ.กาญจนบุรี
พิษแมงมุม-ออกฤทธิ์ทางผิวหนัง-ทางระบบเลือด- คันเป็นตุ่มแดงตามร่างกายเหมือนยุงกัด- หากถูกพิษมาก เกิดตุ่มน้ำพอง ปวดมากขึ้นเรื่อย ๆผิวหนังบริเวณที่ถูกกัดตาย เป็นแผลเป็นขนาดใหญ่

หากมีอาการรุนแรงมาก รีบแจ้งสายด่วน 1669 ขอรับความช่วยเหลือทางการแพทย์โดยเร็วพร้อมนำตัวอย่างแมงมุมที่ถูกกัดมาด้วย เพื่อตรวจสอบว่าเป็นแมงมุมมีพิษหรือไม่